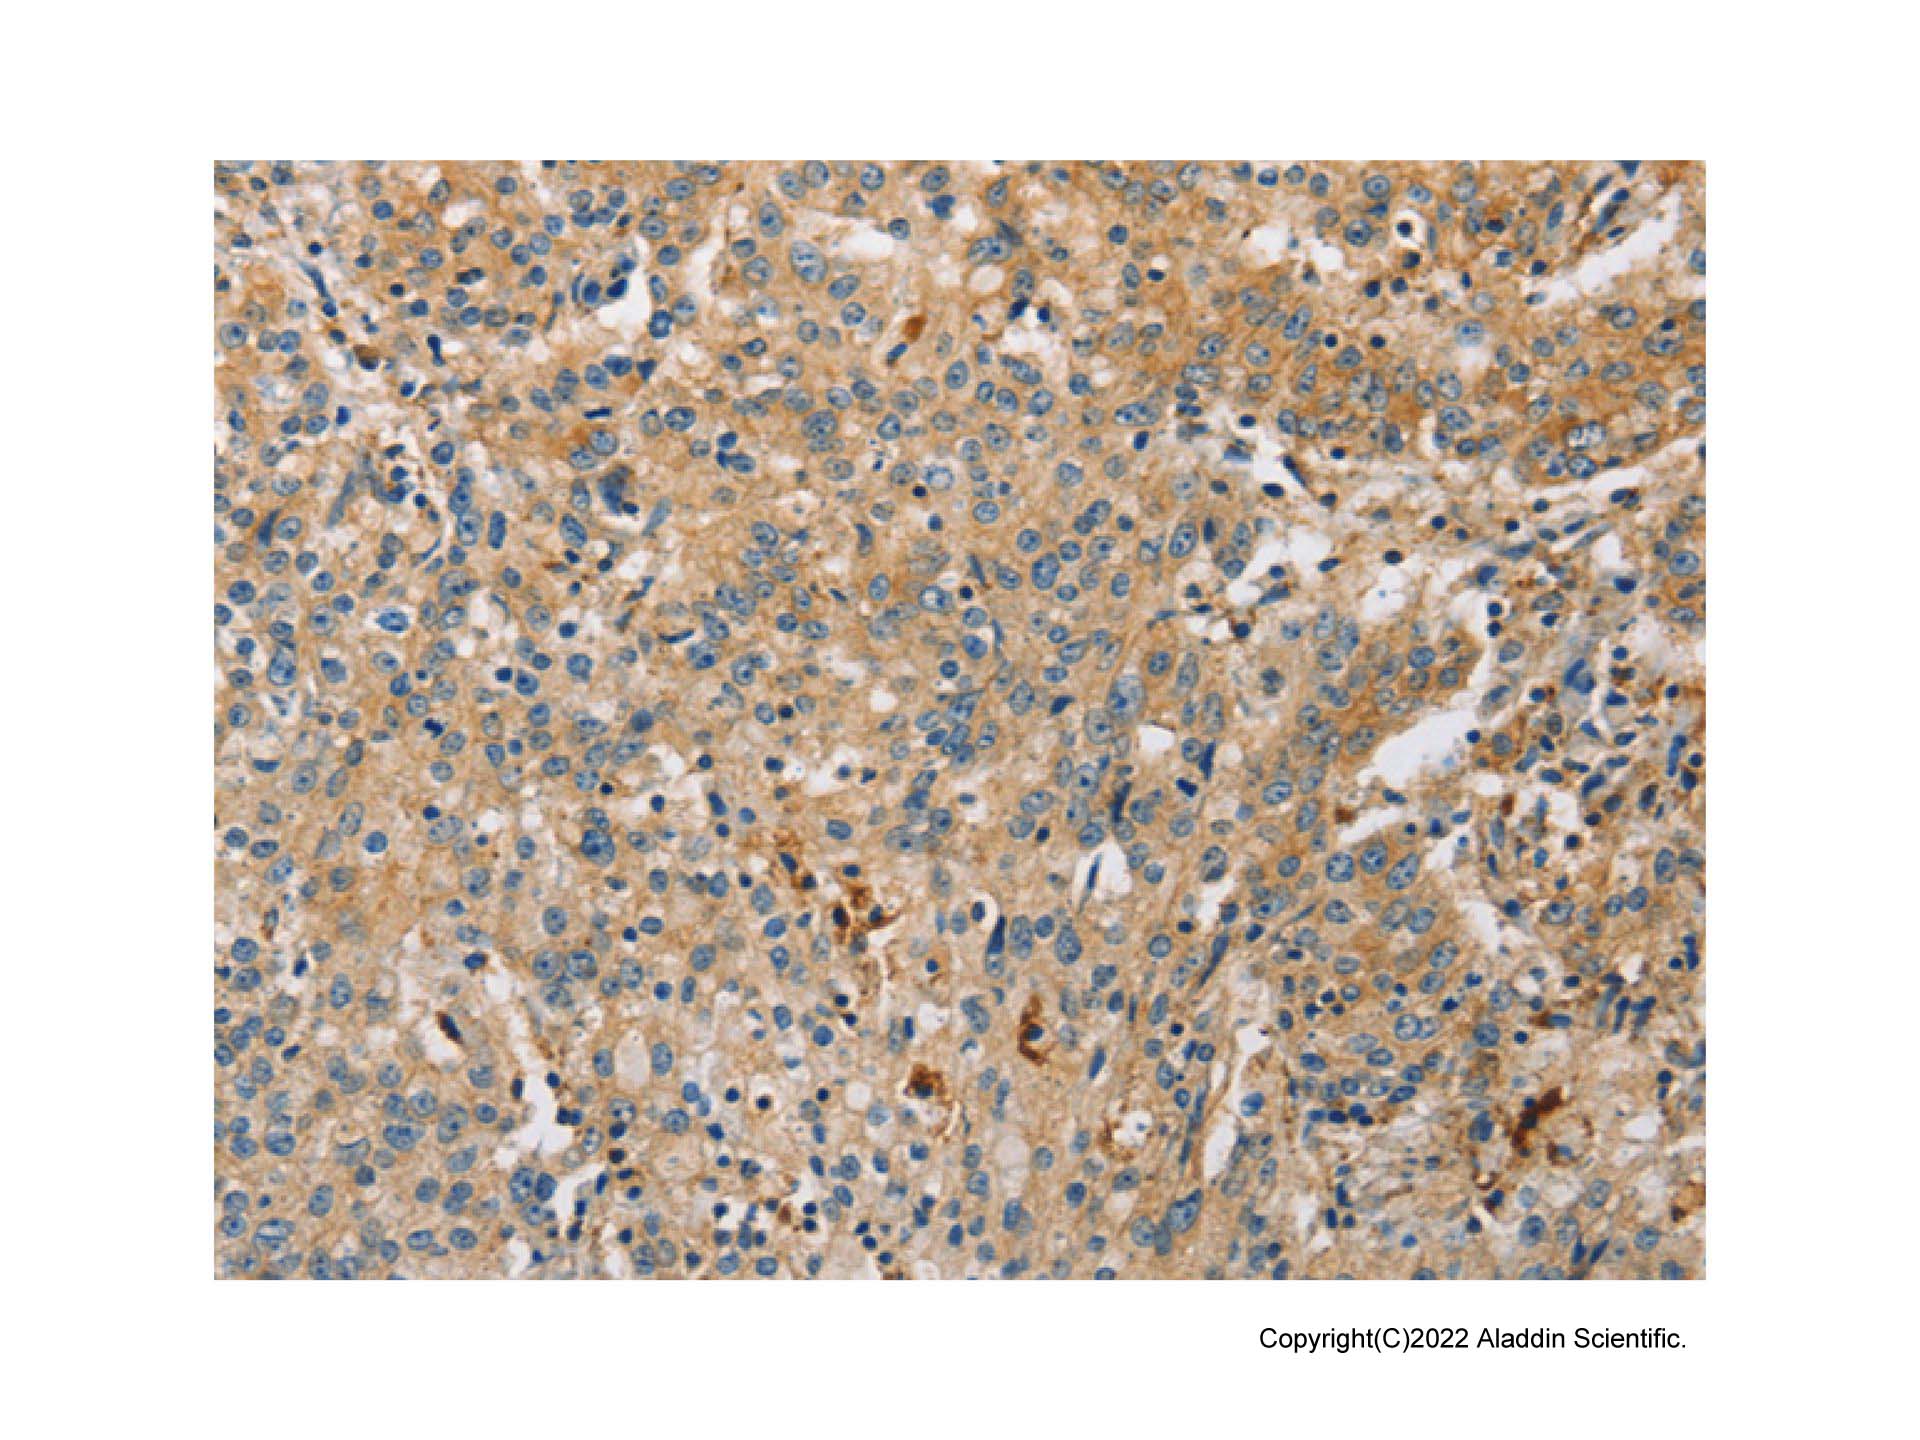

Determine the necessary mass, volume, or concentration for preparing a solution.
This is a demo store. No orders will be fulfilled.
| SKU | Size | Availability |
Price | Qty |
|---|---|---|---|---|
|
Ab089629-10μl
|
10μl |
1
|
$79.90
|
|
|
Ab089629-50μl
|
50μl |
1
|
$239.90
|
|
|
Ab089629-100μl
|
100μl |
Available within 8-12 weeks(?)
Production requires sourcing of materials. We appreciate your patience and understanding.
|
$379.90
|
|
|
Ab089629-1ml
|
1ml |
Available within 8-12 weeks(?)
Production requires sourcing of materials. We appreciate your patience and understanding.
|
$2,899.90
|
|
pAb; Rabbit anti Human ARL8A Antibody; WB, IHC; Unconjugated
| Product Name | ARL8A Antibody - Primary antibody, specific to ARL8A, Rabbit IgG |
|---|---|
| Synonyms | ADP ribosylation factor like 8Aantibody | ADP ribosylation factor like protein 10B antibody | ADP ribosylation factor like protein 8A antibody | ARL 10B antibody | ARL 8A antibody | ARL10B antibody | ARL8Aantibody | FLJ45195 antibody | GIE 2 antibody | GI |
| Specifications & Purity | ExactAb™, Validated, Carrier Free, 0.5 mg/mL |
| Host species | Rabbit |
| Specificity | ARL8A |
| Immunogen | Fusion protein of human ARL8A (AA 1-186) |
| Positive Control | WB: Mouse brain, Rat brain, SK-N-SH lysates. IHC: Human gastric cancer tissue. |
| Conjugation | Unconjugated |
| Grade | Carrier Free, ExactAb™, Validated |
| Product Description |
Rabbit anti Human ARL8A Antibody, Polyclonal, could be used for WB, IHC and so on. |
| Isotype | Rabbit IgG |
|---|---|
| SDS-PAGE | 150 kDa |
| Purification Method | Antigen affinity purified |
| Shape | Liquid |
| Concentration | 0.5 mg/mL |
| Storage Temp | Store at -20°C,Avoid repeated freezing and thawing |
| Shipped In | Ice chest + Ice pads |
| Stability And Storage | Store at 4°C short term (1-2 weeks). Store at -20°C long term (24 months). Upon receipt, it is recommended to aliquot. Avoid freeze/thaw cycle. |
| Activity Type | Activity Value -log(M) | Mechanism of Action | Activity Reference | Publications (PubMed IDs) |
|---|

ARL8A Antibody (Ab089629) - Western Blot
All lanes: ARL8A Antibody (Ab089629) at 1/1000 dilution
Samples: Lysates at 20 µg per lane
Secondary: Goat Anti-Rabbit IgG H&L (HRP) (Ab170144) at 1/10000 dilution
Predicted band size: 21 kDa
Observed band size: 21 kDa
Exposure time: 200.0 s
ARL8A Antibody (Ab089629) - IHC
Immunohistochemistry analysis of paraffin-embedded Human gastric cancer tissue using ARL8A Antibody (Ab089629). High-pressure and temperature Sodium Citrate pH 6.0 was used for antigen retrieval.
| Application | Dilution info |
|---|---|
| WB | 1/500-1/1000 |
| IHC | 1/50-1/100
|